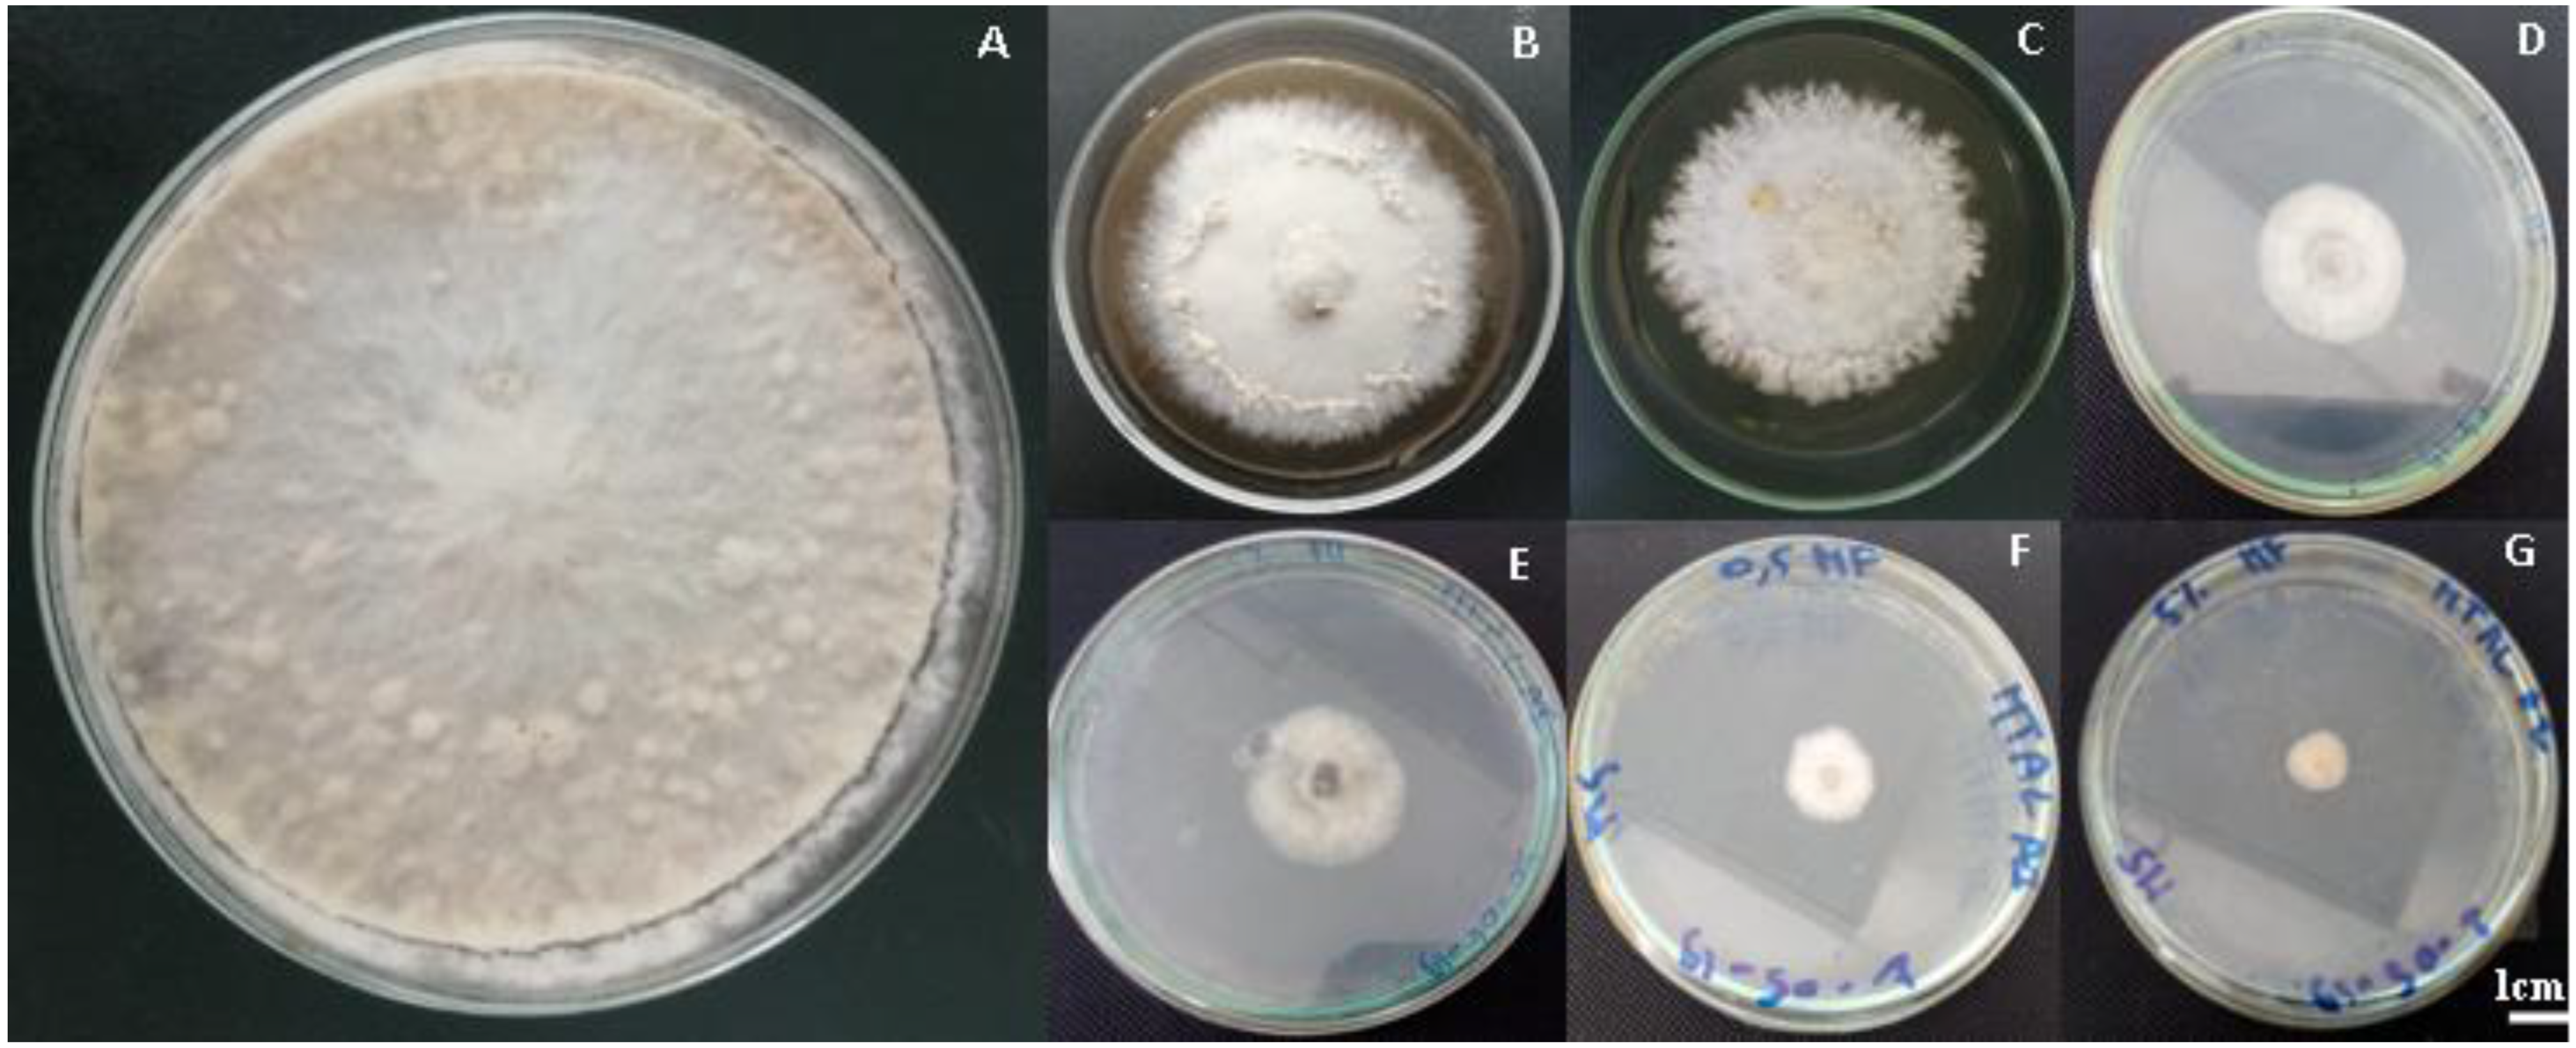
Jof 09 00762 g001

1. Introduction
The agricultural sector plays a fundamental role in Morocco’s economic activities. Likewise, it makes a substantial contribution to the nation’s development since it accounts for 20% of the gross domestic product and employs around 40% of the working-age population [
1]. The apple tree (
Malus domestica) is a highly significant agricultural species in Morocco. Currently, it covers 32,000 ha, accounting for nearly 25% of the total fruit-bearing surface of the Rosaceae family. The cultivation of apple trees has experienced rapid growth, driven by a thriving market, an expanding range of varieties, and a dynamic industry [
2]. The main areas of apple plantations in Morocco are Meknes, Midelt, Khenifra, Haouz Marrakech, Fes, and Ouarzazate [
2]. The Royal Gala variety is largely planted in cropping areas, such as Imouzzer-Kandar [
3]. Apple fruits have worldwide demand, not limited to Morocco, making
Malus pumila Mill a globally significant tree fruit worldwide [
4]. It is a nutritionally important crop that is primarily consumed as fresh fruit, sought after by consumers for its flavor and nutritional qualities. Many countries have emerged as leaders in the production of apple fruit. The Russian apple market generates about 2.6–4.3 million tons of apples per year [
5]. However, a limited percentage of apples is processed into jellies, cooked slices, and juices. Many fungi, including
Monilinia fructigena, which causes brown rot disease and large economic losses even during storage, can infect this fruit and produce fungal infections. Pome and stone fruits are susceptible to brown rot disease, which can also lead to leaf blight and blossom [
6]. Apple fruits are affected by different species of brown rot, either by
M. fructigena or
Phytophthora syringe, as described by Giraud and Bompeix [
7]. Brown rot is among the most serious diseases of apples during storage and can lead to significant losses in the orchard during preharvest. For example, in the UK, losses of apples due to brown rot disease caused by
M. fructigena are estimated to be up to 22% [
8].
In general, postharvest fruit loss caused by plant pathogenic fungi accounts for more than 50% of all fruit and vegetable agricultural products [
9]. Fungi of the genus
Monilinia are present worldwide and cause economically important damage [
10]. Several
Moniliia species responsible for brown rot disease [
11] affect pome and stone fruits economically, both in pre- and postharvest conditions. Brown rot, caused by three species of the
Monilinia, mainly
M. laxa, (Aderh & Rulh) Honey,
M. fructigena Honey in Whetzel, and
M. fructicola (Win) Honey, is the major disease in the European Mediterranean stone fruit production regions, including Spain [
12]. The disease can reach a high incidence, leading to significant losses during storage [
13,
14].
M. fructigena, one of the three species, is one of the most important fungal pathogens that causes brown rot in apples and heavily affects fruit production [
13]. The pathogen is frequently found in Europe and Asia [
10]. For instance,
M. fructigena is the predominant causal agent of brown rot disease in Serbia (76.48%) [
15]. The majority of fruit losses during storage are caused by diseases due to different microbial infections, leading to 25–50% fruit deterioration [
16]. The disease is mainly controlled by synthetic fungicides. However, fungicides are harmful to human health and affect negatively the environment [
17]. In addition to satisfying the increasing demand for food supplies, the food industry sector has prioritized consumer health and safety [
18]. In this regard, the only available treatment for managing this disease is through field fungicide spraying. However, it is unfortunate that no chemicals are allowed in the EU after the harvest of stone fruit [
19]. Therefore, the use of these synthetic pesticides should be reduced.
Many chemicals classified as GRAS have been used to extend fresh fruit shelf life during storage, such as bicarbonate, calcium carbonate, and silicate [
17]. These organic and inorganic salts were also found to be quite promising [
20]. To increase the effectiveness of electrolysis and replace the use of NaCl, which is known to produce corrosive by-products that harm equipment, operators, and consumers, several organic and inorganic salts were evaluated in the past. Among these salts was sodium bicarbonate (NaHCO
3), a food additive which is used in various commodities [
13]. It has also been reported to be effective in preventing postharvest diseases in a wide range of fruit. It is widely used in the food industry as a food additive and is allowed with no restrictions for many applications under European and North American regulations [
21]. Moreover, SBC is a very attractive alternative because it is readily available, inexpensive, and has little risk of phytotoxicity at low concentrations (1–4%) [
12]. Interestingly, trisodium phosphate (TSP), which is defined as a GRAS substance by the US Food and Drug Administration, can reduce brown rot disease and inhibit
M. fructicola growth [
17]. This inorganic compound is highly soluble in water and produces alkaline solutions.
Our study aimed to evaluate the innovative biological and integrated approaches to control brown rot disease in apples by investigating the impact of different food additives (GRAS) such as magnesium, sodium, sulphate anhydrous, ammonium carbonate, ammonium bicarbonate, copper sulphate, and other salts on the development of M. fructigena both in in vitro and in vivo trials. Therefore, we studied the effect of salts on the mycelial growth of the pathogenic fungus, the inhibition of spore germination, and the effect of different treatments on germ tube elongation. In the in vivo experiments, the severity and incidence of the disease on artificially infected fruits as affected by salt treatments were assessed. In addition, different indices of fruit quality, such as weight loss, titratable acidity, total soluble balances, and firmness were recorded. The treatments showing a high inhibition rate and low severity were then evaluated in a semi-commercial trial at two different temperatures, 22 and 4 °C.
4. Discussion
In recent years, there has been a growing recognition of the significance of employing food additives for the safeguarding of fresh fruits from spoilage [
38]. The postharvest application of these additives offers a potential alternative to the use of chemical fungicides, thereby catering to the demand for organic or “no-residue” fresh fruit. This is particularly important given the current emphasis on reducing fungicide usage [
39]. Brown rot, a fungal disease, poses a significant threat to fruit production as it can cause considerable losses. This disease affects fruits both in orchards, with losses ranging from 50% to 75%, and during postharvest stages such as transportation and storage, leading to additional losses of 25% to 50% [
39].
This study has provided evidence that specific food additives possess fungistatic properties, effectively inhibiting the germination of conidia and the growth of mycelium associated with brown rot caused by the pathogen
M. fructigena. These findings suggest the potential utilization of these additives as an alternative to chemical treatments. Specifically, our study revealed that various food additives, when applied at different doses, can effectively suppress the growth of
M. fructigena in both an in vitro culture medium and artificially inoculated apples. In the in vitro experiments, some food preservatives exhibited remarkable inhibitory effects on the mycelial growth of the pathogen, with inhibition rates exceeding 88%. Notable examples include sodium bicarbonate, sodium carbonate, and sodium hydroxide [
39]. However, specific additives such as ammonium bicarbonate, copper sulfate, and magnesium chlorite did not demonstrate a significant reduction in the disease when tested on Petri dishes.
Several growth tests have been conducted to investigate how specific elements affect the development and growth of pathogens and the mycelial form of hyphae in a specific fungus. Under controlled conditions, the mycelium in the control dishes displayed typical characteristics and produced spores after 15 days of incubation. However, it was observed that certain salts, such as copper sulphate, exhibited the ability to destroy or deform the pathogen’s mycelium, rendering it finer and weaker.
Previous studies have highlighted the effectiveness of carbonate salts against various postharvest fungi affecting fruits and vegetables [
39,
40]. Similarly, SMBS and PMBS salts demonstrated significant efficacy in inhibiting the growth of
G. citri-aurantii,
P. italicum, and
P. digitatum, with all tested concentrations completely inhibiting their growth after 7 days of incubation at 25 °C [
41]. Furthermore, our findings indicated that sodium bicarbonate (4%) completely inhibited the mycelial growth and spore germination of Aspergillus in an in vitro assay [
42]. Other salts and food additives, such as ammonium bicarbonate, ammonium carbonate, sodium bicarbonate, sodium carbonate, potassium bicarbonate, and potassium carbonate, exhibited enhanced potential to inhibit the mycelial growth of
B. cinerea across all tested concentrations [
43]. At certain concentrations, researchers have also discovered that hydrogen peroxide, potassium sorbate, sodium bicarbonate, and chitosan can effectively impede the mycelial growth of the
Colletotrichum sp. strain [
43]. Similarly, these salts exhibited the complete inhibition (100%) of the radial mycelial growth of
Colletotrichum siamense, the anthracnose-causing agent [
44].
Carbonate salts have consistently demonstrated effective control over various postharvest fungi in fruits and vegetables, contributing to improved fruit firmness and reduced decay [
45]. However, the precise mode of action of these salts in reducing postharvest diseases is not yet fully understood. It is suggested that their inhibitory effects may be attributed to the presence of salt residues in the infection sites occupied by the pathogen [
46]. Additionally, the strong inhibitory effect of these substances on pathogenic mycelial growth underscores their potential as a viable strategy for managing postharvest diseases. Many coating formulations incorporate salts, such as bicarbonates and parabens, which have shown significant reduction rates in the brown rot incidence caused by
M. fructicola. Notably, a coating formulation containing 1.0% potassium sorbate exhibited the highest effectiveness with a reduction rate of 28.6% [
26].
The investigation of various treatments on the interaction with pathogen spores yielded diverse outcomes. Notably, copper sulphate, sodium bicarbonate, ammonium bicarbonate, and sodium carbonate exhibited a successful inhibition of
M. fuctigena spore germination, with inhibition rates ranging from 21.94% for sodium phosphate dibasic to 100% for copper sulphate. Conversely, other salts demonstrated only weak inhibitory effects on germination [
42].
In a separate study, the application of SMBS and PMBS significantly reduced the incidence, severity, and sporulation of blue mold and green mold caused by
P. digitatum,
P. italicum, and
G. citriaurantii on ‘Valencia’ oranges, as compared to a control group [
42]. Another study found that ammonium carbonate completely inhibited spore germination at a concentration of 10 mM [
46]. Furthermore, treatment with hydrogen peroxide and potassium sorbate demonstrated the inhibition of conidia germination in
Colletotrichum sp. [
47].
Food additives have proven effective against a wide range of pathogens. For instance, a preharvest application of potassium phosphate significantly reduced the incidence of citrus brown rot caused by
Phytophthora spp., with incidences decreasing by 40–60% in harvested and inoculated lemons for up to 75 days post-treatment [
45]. Additionally, various salts such as Na
2CO
3, NaClO, NaHCO
3, CaCl
2, and NaCl completely inhibited conidial germination in banana-crown-rot-causing fungal pathogens such as
Lasiodiplodia theobromae,
Colletotrichum musae,
Thielaviopsis paradoxa, and
Fusarium verticillioides for 2 days. These salts also displayed complete control of conidial germination in all pathogens for 7 days when supplemented with a surfactant [
48]. Furthermore, the treatments exhibited noticeable effects on the germination and germ tubes of the pathogen. While the spores did germinate, their germ tubes were significantly reduced compared to the control group. Sodium bicarbonate achieved the highest reduction, reaching up to 95.53% after 24 h of incubation at 25 °C. Conversely, microscopic examination of conidia treated with substances that displayed high germination inhibition rates revealed the complete absence of germ tubes and occasional spore deformation, as observed with spores treated with 5% copper sulphate.
A series of in vivo tests were conducted to evaluate the effectiveness of various food preservatives in preventing the occurrence and severity of disease in artificially infected apple fruits. Results indicated that the treatments differed significantly in their ability to inhibit the disease. Specifically, primary screenings revealed that ammonium bicarbonate treatments demonstrated a reduction in disease incidence by as much as 66.67% after 5 days of incubation, while other treatments such as magnesium chlorite showed negligible effects compared to untreated fruits.
Further experimentation demonstrated that a combination of copper sulphate, ammonium bicarbonate, sodium hydroxide, sodium carbonate, and sodium bicarbonate treatments administered 24 h before infection significantly reduced the incidence and severity of disease on apples. These findings suggest that certain food preservatives can be effective in preventing and reducing the severity of disease in apples.
Several salts, including sodium benzoate and sodium methylparaben, have shown improvement as alternative methods for controlling sour rot caused by
Geotrichum citri-auranti. These salts have demonstrated curative effects by reducing the incidence and severity of the disease [
49]. Numerous studies have highlighted the potential of various organic and inorganic salts classified as food additives or generally recognized as safe (GRAS) compounds. Examples include potassium silicate, sodium methylparaben, potassium sorbate, and sodium benzoate, which have been effective in controlling various postharvest diseases such as green mold and blue mold [
50]. However, the application of copper sulfate has shown phytotoxic effects on fruit rinds, leading to visible darkening, and sinking at the inoculation point. Similar observations were made by Martínez-blay et al. [
42], who discovered the phytotoxicity of sodium metabisulfite (SMBS), potassium metabisulfite (PMBS), aluminum sulfate, and aluminum potassium sulfate on citrus fruit [
42]. In contrast, the treatment of naturally infected fruits with a 4% solution of sodium bicarbonate successfully controlled the disease caused by
Aspergillus, achieving a 100% control rate and extending the storage life to 28 days [
43]. Furthermore, the combination of these food additives has shown promising results in reducing postharvest diseases, including decaying disease and browning in various fruits. Whangchai et al. [
51] reported that ozone, when combined with oxalic or citric acid, could serve as a partial alternative to sulfur dioxide fumigation for controlling decay disease.
In a recent study, the most effective treatments for various diseases, without the need for additional heat treatments, were found to be either potassium sorbate or a sequence of hydrogen peroxide followed by potassium phosphate [
52]. Postharvest applications of sodium bicarbonate (SBC) have also been shown to potentially control postharvest diseases in a wide range of fruits, including sweet cherries [
53]. Recognizing its significant control potential, sodium was combined with
Metschnikowia fructicola and ethanol to manage postharvest diseases in grapes [
54]. Additionally, researchers have suggested that preharvest calcium treatment, when combined with specific storage atmospheres and fruit injury management, could significantly influence postharvest decay caused by
M. fructigena [
38].
Scientific investigations demonstrated the favorable outcomes of applying cupric salts, specifically copper hydroxide, to cocoa trees to control the brown rot in cocoa pods [
55]. In a comprehensive three-year study, the preharvest application of calcium salts on apple fruits revealed a reduction in postharvest losses caused by
M. fructigena, thereby minimizing the long-term risks of contamination, such as fruit injury and infection [
38]. Furthermore, research results indicated that these salts exhibit a direct antifungal effect on
P. digitatum and possess the ability to induce citrus defense mechanisms against postharvest rot [
13]. In the context of controlling anthracnose, the effectiveness of various salts was assessed, with ammonium carbonate (3%) followed by sodium carbonate (2%), either alone or in combination with other salts, demonstrating positive effects in reducing the occurrence of
C. gloeosporioides in both naturally and artificially inoculated fruits [
56].
Subsequently, food additives that exhibited both a low severity rate and an inhibition rate of mycelial growth exceeding 88% in in vitro experiments were selected for testing on apple fruit quality parameters after 15 days of artificial incubation. Employing a preventive approach, the selected treatments were applied within 24 h before inoculation with the bacterial pathogen’s suspension. Remarkably, our study confirmed that the chosen treatments did not compromise the quality of the apples after testing.
Furthermore, the application of sodium bicarbonate as a treatment exhibited various beneficial effects on the quality of yellow pitahaya (
Selenicereus megalanthus) during both storage and subsequent shelf life [
57]. These effects included reduced weight loss, preserved color, and firmness, as well as slowed changes in total soluble solids, titratable acid content, and pH. Another approach involved treating mango fruit with a combination of salicylic acid or potassium phosphonate and a fruit dip containing aqueous sodium bicarbonate, resulting in maintained quality attributes such as pH, total soluble solids, titratable acidity, firmness, and color [
58]. The observed outcomes can be attributed to the specific treatments applied, as the storage temperature did not significantly impact the fruit quality. It is noteworthy that other researchers have also conducted experiments under similar storage conditions, supporting these findings. Frans et al. [
59] demonstrated that bell pepper cultivars, artificially infected and stored under modified atmosphere packaging conditions, maintained relatively stable levels of total titratable acid, total soluble solids, and vitamin C concentrations for up to 14 days. These conditions were designed to resemble unrefrigerated shelf-life conditions at a challenging temperature of 20 °C.
Over the past two years, numerous studies have been conducted to investigate the impact of storage conditions in conjunction with other treatments on postharvest decay and disease in fruits and vegetables. For instance, in the case of Embul bananas, storage at cold temperatures for up to 21 days was found to effectively control postharvest decay [
60]. Similarly, storing Keitt mangoes at 7 °C extended their lifespan for up to six weeks, while storage at 13 °C was shown to be optimal for preserving their quality for up to 21 days without causing chilling injury [
61]. Salicylic acid treatments applied during cold storage also significantly improved the storage life of Chimarrita peaches [
62]. In addition, modified atmosphere packaging was found to be a valuable tool in preventing postharvest internal rotting of bell peppers caused by
Fusarium spp. under conventional storage temperatures of 7–16 °C [
59].
Storage temperature is a crucial factor in controlling postharvest fungal disease, as demonstrated by a recent study on the effect of temperature on the volatile organic compound (VOC) profile of garlic [
63]. For instance, hexanal, calcium chloride, and cold storage are recommended to maintain the quality of mango fruit [
64]. Additionally, the use of
Bacillus subtilis strain QST 713 in the alternative fight against postharvest disease in greenhouse tomatoes was found to be effective when combined with storage at 13 °C for no more than 12 days [
65]. On the other hand, a study on the storage of potatoes found no significant difference in the effectiveness of different temperatures [
65].